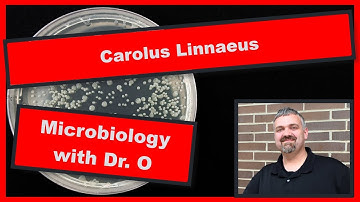
Naming Microbes:  Microbiology

⬇ DOWNLOAD NOW
Kalau muncul iklan pop-up, tutup lalu klik tombol kembali
Download lagu How to Name a Microbe secara gratis hanya untuk keperluan promosi. Dukung artis favorit kamu dengan membeli musik original di iTunes atau platform resmi lainnya.
 How To Name Bacteria? - Biology For Everyone
How To Name Bacteria? - Biology For Everyone
 Bacteria 3D Animation
Bacteria 3D Animation
 Microorganisms | The Dr. Binocs Show | Educational Videos For Kids
Microorganisms | The Dr. Binocs Show | Educational Videos For Kids
 Microbes in our nails under microscope | Dust and Germs in nails - 400x Microscopic View
Microbes in our nails under microscope | Dust and Germs in nails - 400x Microscopic View
Naming Microbes: Microbiology
Naming Microbes: Microbiology
 How To Write Bacteria Name? - Biology For Everyone
How To Write Bacteria Name? - Biology For Everyone
 Microbes in the nails: microorganisms effects 2021
Microbes in the nails: microorganisms effects 2021
 Different shapes of bacteria
Different shapes of bacteria